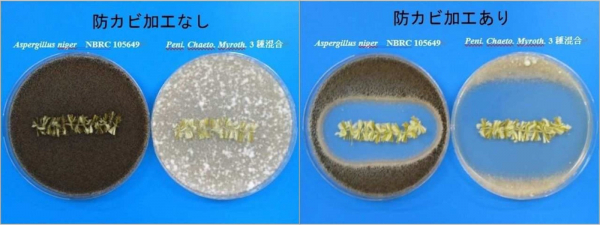

和装、洋装、意匠撚糸、寝装、宝飾品といった事業を中心に事業展開をする創業160年の堀田丸正株式会社(本社:東京都中央区、代表取締役社長:三好秀樹)は、2021年4月8日(木)から環境に優しい和紙糸で作るインテリアグリーン「PAPER CoCo(ペーパーココ)」作成キットを応援購入サービス「Makuake」から販売を開始致します。

世の中では、ニュースタンダードと呼ばれる新しいライフスタイルが確立し、「おうち時間」を快適で充実した環境で過ごす事がより求められる様になりました。
創業から160年を迎える堀田丸正株式会社の強みの一つである糸の企画開発として、 まず「環境に配慮したモノづくり」を進めました。そして、『より手軽で、身近に日常生活に彩を添える』という想いを、マテリアルの可能性や創造性の取り組みの新たな挑戦から生まれたのが「PAPER CoCo(ペーパーココ)」です。
堀田丸正株式会社で企画生産した「PAPER CoCo(ペーパーココ)」は和紙で作られた糸を水苔(みずごけ) *1として使用する為、水分をたっぷりと含むので水やりの手間が減ります。
また、土の代わりにココナッツチップ*2の使用で手や部屋が汚れにくいため、気軽に楽しめるインテリアグリーンの制作キットになります。
また、SDGsの取り組みの一環として、「PAPER CoCo(ペーパーココ)」で使用される糸(ペーパーココヤーン) は、100%天然繊維の綿と和紙で出来ている糸の為、地中で分解され土に還るとても自然環境に優しい糸を企画開発致しました。
【PAPER CoCo紹介】
■「PAPER CoCo(ペーパーココ)」とは、和紙糸=(PAPER)を巻いて、ココナッツの様な形=(CoCo)をしたハンギング出来るインテリアグリーンです。ガーデニング未経験者でも簡単に作成でき、小さなスペースでもお飾り頂けます。
■写真映えする、オシャレな植物:ペーパーココヤーン(和紙糸)は全11色展開です。季節やお部屋のインテリアに合わせるなど、お客様のお好みでオリジナルを作成頂けます。
創業から160年を迎える堀田丸正株式会社の強みの一つである糸の企画開発として、 まず「環境に配慮したモノづくり」を進めました。そして、『より手軽で、身近に日常生活に彩を添える』という想いを、マテリアルの可能性や創造性の取り組みの新たな挑戦から生まれたのが「PAPER CoCo(ペーパーココ)」です。
堀田丸正株式会社で企画生産した「PAPER CoCo(ペーパーココ)」は和紙で作られた糸を水苔(みずごけ) *1として使用する為、水分をたっぷりと含むので水やりの手間が減ります。
また、土の代わりにココナッツチップ*2の使用で手や部屋が汚れにくいため、気軽に楽しめるインテリアグリーンの制作キットになります。
また、SDGsの取り組みの一環として、「PAPER CoCo(ペーパーココ)」で使用される糸(ペーパーココヤーン) は、100%天然繊維の綿と和紙で出来ている糸の為、地中で分解され土に還るとても自然環境に優しい糸を企画開発致しました。
【PAPER CoCo紹介】
■「PAPER CoCo(ペーパーココ)」とは、和紙糸=(PAPER)を巻いて、ココナッツの様な形=(CoCo)をしたハンギング出来るインテリアグリーンです。ガーデニング未経験者でも簡単に作成でき、小さなスペースでもお飾り頂けます。
■写真映えする、オシャレな植物:ペーパーココヤーン(和紙糸)は全11色展開です。季節やお部屋のインテリアに合わせるなど、お客様のお好みでオリジナルを作成頂けます。

■糸にはカビを生えにくくする防カビ加工を染色段階で行っております。
※防カビ加工は、カビを生えにくくする加工であり全てのカビに対して効果があるものではありません。
【株式会社ワールドインダストリー富山 防カビ試験結果】
※防カビ加工は、カビを生えにくくする加工であり全てのカビに対して効果があるものではありません。
【株式会社ワールドインダストリー富山 防カビ試験結果】
■「PAPER CoCo(ペーパーココ)」作成キット内容
(1)ヤシの実チップ:50g
(2)ペーパーココヤーン(和紙糸40% 綿60%):40g・40m
(3)ワイヤー約15cm:1個
(4)ネット:1枚
■箱サイズ:180mmx125mmx60mm
■生産国:日本製(MADE IN JAPAN)
【商品紹介】
■先着50名様限定
観葉植物付き「PAPER CoCo(ペーパーココ)」作成キット1セット 1,800円(送料込み)
観葉植物(アイビー)1個とペーパーココ作成キット1個のセットになります。
どの植物を選べば良いのか不安な方におすすめです。
※ペーパーココヤーン(和紙糸)の色は11色の中からお好みの色をお選び頂けます。
■先着100名限定特別価格
「PAPER CoCo(ペーパーココ)」作成キット1セット 1,600円(送料込み)
通常販売予定価格1,650円+送料660円(沖縄、北海道、離島除く)を特別価格でご購入頂けます。
お客様のお好みの植物をお好みの色のペーパーココヤーン(和紙糸)を使用して作成頂けます。
※観葉植物は含まれておりません。
■ペーパーココヤーン(和紙糸)3色セット 2,100円(送料込み)
お好みの色のペーパーココヤーン(和紙糸)を3色お選び頂けるセットです。※糸だけのセットです。観葉植物、ココナッツチップは含まれておりません。「PAPER CoCo(ペーパーココ)」以外にご使用したい方にお勧めです。
■ペーパーココヤーン(和紙糸)全11色セット 7,700円(送料込み)
※全11色の糸のみのセットになります。観葉植物、ココナッツチップは含まれておりません。
(1)ヤシの実チップ:50g
(2)ペーパーココヤーン(和紙糸40% 綿60%):40g・40m
(3)ワイヤー約15cm:1個
(4)ネット:1枚
■箱サイズ:180mmx125mmx60mm
■生産国:日本製(MADE IN JAPAN)
【商品紹介】
■先着50名様限定
観葉植物付き「PAPER CoCo(ペーパーココ)」作成キット1セット 1,800円(送料込み)
観葉植物(アイビー)1個とペーパーココ作成キット1個のセットになります。
どの植物を選べば良いのか不安な方におすすめです。
※ペーパーココヤーン(和紙糸)の色は11色の中からお好みの色をお選び頂けます。
■先着100名限定特別価格
「PAPER CoCo(ペーパーココ)」作成キット1セット 1,600円(送料込み)
通常販売予定価格1,650円+送料660円(沖縄、北海道、離島除く)を特別価格でご購入頂けます。
お客様のお好みの植物をお好みの色のペーパーココヤーン(和紙糸)を使用して作成頂けます。
※観葉植物は含まれておりません。
■ペーパーココヤーン(和紙糸)3色セット 2,100円(送料込み)
お好みの色のペーパーココヤーン(和紙糸)を3色お選び頂けるセットです。※糸だけのセットです。観葉植物、ココナッツチップは含まれておりません。「PAPER CoCo(ペーパーココ)」以外にご使用したい方にお勧めです。
■ペーパーココヤーン(和紙糸)全11色セット 7,700円(送料込み)
※全11色の糸のみのセットになります。観葉植物、ココナッツチップは含まれておりません。

【プロジェクト紹介】
■プロジェクト名:老舗メーカーの挑戦!和紙糸で作るインテリアグリーン「PAPER CoCo(ペーパーココ)」作成キット
■プロジェクトページURL:https://www.makuake.com/project/papercoco/
■プロジェクト期間:2021年4月8日(木)~2021年5月30日(日)
■配送期間:2021年6月下旬~7月末(完了)
*1水苔(水苔)
ガーデニングに使用される、通気性が良く、水はけ・水もちが良くなる優れた植え込み材料の1つ。観葉植物の植え込み材として使用するほか、植物をハンギング(吊り下げて)植え付けた際に、隙間から土がこぼれない様に土留(つちどめ)として使用されるもの。
*2ココナッツチップ
ココナッツの殻をチップ状に砕いた土の代わりに使用されるもの。土に比べ扱いやすく、軽く、保水性・通気性・水はけが良く、何よりも手や部屋が汚れない土壌材料。
■会社概要
称号 :堀田丸正株式会社(Marusho hotta Co.,Ltd)
代表者 :代表取締役社長 三好 秀樹
本社 :〒103-0022 東京都中央区日本橋室町4-1-11
設立 :1933年2月(創業1861年)
資本金 :2,937百万円(2020年3月末現在)
公式サイト :http://www.pearly-marusho.co.jp/
■事業内容
1861年に創業して今年で160年。
和装・洋装・意匠撚糸・寝装・宝飾品などを取り扱う専門商社。
本件に関する問合せは下記までお願い致します。
堀田丸正株式会社 マテリアル事業部 担当:小林
E-mail:d-kobayashi@hotta-marusho.co.jp
■プロジェクト名:老舗メーカーの挑戦!和紙糸で作るインテリアグリーン「PAPER CoCo(ペーパーココ)」作成キット
■プロジェクトページURL:https://www.makuake.com/project/papercoco/
■プロジェクト期間:2021年4月8日(木)~2021年5月30日(日)
■配送期間:2021年6月下旬~7月末(完了)
*1水苔(水苔)
ガーデニングに使用される、通気性が良く、水はけ・水もちが良くなる優れた植え込み材料の1つ。観葉植物の植え込み材として使用するほか、植物をハンギング(吊り下げて)植え付けた際に、隙間から土がこぼれない様に土留(つちどめ)として使用されるもの。
*2ココナッツチップ
ココナッツの殻をチップ状に砕いた土の代わりに使用されるもの。土に比べ扱いやすく、軽く、保水性・通気性・水はけが良く、何よりも手や部屋が汚れない土壌材料。
■会社概要
称号 :堀田丸正株式会社(Marusho hotta Co.,Ltd)
代表者 :代表取締役社長 三好 秀樹
本社 :〒103-0022 東京都中央区日本橋室町4-1-11
設立 :1933年2月(創業1861年)
資本金 :2,937百万円(2020年3月末現在)
公式サイト :http://www.pearly-marusho.co.jp/
■事業内容
1861年に創業して今年で160年。
和装・洋装・意匠撚糸・寝装・宝飾品などを取り扱う専門商社。
本件に関する問合せは下記までお願い致します。
堀田丸正株式会社 マテリアル事業部 担当:小林
E-mail:d-kobayashi@hotta-marusho.co.jp





